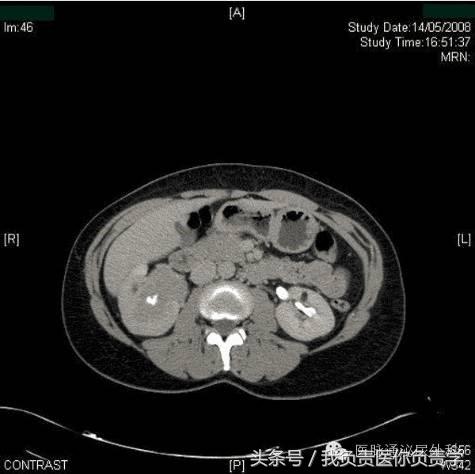
57岁女性出现一次无痛血尿,女性42岁全程无痛性肉眼血尿

患者,女,60岁,因近期出现肉眼可见无痛血尿转至急诊科。患者去年曾出现过几次类似症状,但随后均自发消退。患者此前将该症状归结于妇科疾病(绝经5年)。
患者发病前一天总体感觉不适,但否认发热、排尿困难或尿频、尿急。过去两年中,体重减轻5kg。
病史,患有甲状腺功能减退症,曾接受甲状腺素治疗。手术史,刮宫术和扁桃体切除术。
患者无已知的药物或食物过敏史,否认吸烟、滥用药物或酗酒。无肾结石或复发性尿路感染史。
体格检查和诊断检查
头颈部检查结果正常。肺部听诊显示双侧正常呼吸音,无哮鸣音或湿罗音。患者心音规则,右侧第二肋间2/6收缩期杂音最大。否认腹部扩张和压痛,未触及肿块,无腹膜刺激征象存在。未注意到外周水肿,触诊外周脉冲,神经学检查未见异常。进行了妇科评估(阴道镜检查和阴道超声检查),无病理学发现。
实验室分析(完整血细胞计数、凝血研究和基本代谢检查)显示血红蛋白水平和血小板计数正常,无凝血病。未发现电解质异常。尿液试纸测试未观察到血尿,尿培养阴性。尿细胞学检查对恶性细胞呈阳性。进行膀胱镜检查,显示尿道正常,膀胱由正常粘膜覆盖,未见外生性病变和活动性出血。腹部和盆骨静脉造影CT如图1。
图1

根据病史、体格检查和诊断检查,应作何诊断?
1、肾结石
2、尿路上皮癌
3、外部肾压迫
4、复杂性肾囊肿
讨论
CT尿路造影的轴向图像以及相关的矢状重建,显示右肾盂中存在大面积充盈缺损。充盈缺损延伸并占据右肾盂中多数空间,造成肾造影显影期质量效应和肾脏增强的相对延迟(图2,3)。放射学表现和无痛性血尿及尿液细胞学阳性共同指示上尿路上皮癌。
图2
图3

上尿路上皮癌是指尿道中从肾盏到输尿管口的尿路上皮细胞的恶性变化。此类癌症相对少见,仅占肾肿瘤的5%~7%和尿路上皮肿瘤的约5%。该疾病的实际发病率随着人口老龄化增加。上尿路肿瘤患病人群比膀胱癌患病人群的年龄更大;其在40岁以下人群中十分少见,该疾病患者的平均年龄为65岁。上尿路肿瘤每年的发病率为10/10W。
男性发生上尿路肿瘤的概率是女性的2倍。白种人和黑种人发生上尿路肿瘤的风险比为2:1;但是数据显示,就该疾病年死亡率来说,黑种人男性高于白种人男性(7.4% vs 4.9%),女性高于男性(6.1% vs 4.4%)。
已提出的上尿路肿瘤原因与膀胱癌相似,包括环境因素(吸烟)、职业暴露(苯胺染料)和抗炎药物(非那西丁)或化学药物(环磷酰胺,异环磷酰胺)治疗。已在巴尔干肾病中鉴定了家族性关联,尽管在此类病例中,未鉴别的环境诱导可能是潜在病因。
血尿为最常见的症状,通常见于56%~98%的患者,这也是上尿路肿瘤最常用的诊断依据。侧腹痛仅次于血尿,发生于30%的病例中。疼痛范围由模糊疼痛(采集系统阻塞引起)到类似肾绞痛的急性疼痛(通常认为由血栓的急性阻塞引起)。约15%患者无明显症状,偶然在其他疾病诊断的成像研究中诊断出该疾病。
上尿路肿瘤晚期患者可能出现食欲不佳、体重减轻、侧腹或腹部肿块以及骨骼疼痛。传统上,使用静脉内肾盂造影术诊断上尿道肿瘤;但CT尿路造影是现在的主要诊断方式。使用CT尿路造影检查上尿路恶性疾病的灵敏度接近100%,其*特中**异性为60%,阴性预测值为100%。但是CT尿路造影的辐射量更大,需要静脉注射造影剂。
X射线透射充盈缺损、上尿道部分阻塞或不完全填充及采集系统的非可视化都是上尿路肿瘤的典型表现。充盈缺损指示结石、血块、外部压迫或真球菌。可通过肾脏超声检查或增强CT检查排除结石。
如果仍不能确诊或者需根据输尿管镜检评价来调整治疗方案,则需进行伴或不伴活检的内窥镜检查。输尿管镜检查是评估上尿路上皮癌的最有效工具。随着光学、输尿管软镜技术和内窥镜设备的进步,肿瘤可视化和采样得到改善。
上尿路上皮癌最大的预后因素为病理分级和分期。最初输尿管活检和最终病理标本之间具有高达90%的组织学相关性;但是由于活检标本尺寸较小和组织取样的深度,肿瘤分期结果未显示相同强度的相关性。在一个包含40例分期尿路上皮肿瘤的病例系列中,45%此前认定为病例性Ta的肿瘤在完全切除时上升为T1-T3。输尿管镜活检未能可靠地预测肿瘤分期;因此需结合肿瘤分级、肿瘤内窥镜可视化和放射学表现才可对肿瘤分期做出最佳预测。
因为尿脱落细胞学检查是非特异性的,故其可用性受限。即使应用选择性输尿管细胞学标本,所得诊断结果的准确率仅有60%。已证实使用生理盐水洗涤或刷活检可改善诊断率,其灵敏度和特异性几近90%。
上尿路肿瘤的标准治疗方法为肾输尿管及膀胱袖套状切除术。但是,经皮和内窥镜技术的改善允许独立肾或非摘除手术理想候选患者行较保守的肾保留手术。考虑到规定标准,将根治性肾输尿管切除术(结合膀胱袖状切除)作为大型、高级别、单一或多病灶、非侵袭性或侵袭性肾盂或近端输尿管肿瘤患者的治疗选择。部分切除后具有多病灶风险且同侧复发率高,因此根治性方法更可取。
包括完全开放手术和完全腹腔镜下肾输尿管切除手术,或两者结合在内(如腹腔镜肾脏切除术结合开放性远端壁内输尿管切除术)的方法可供应用。机器人辅助肾小叶切除术(微创手术)的安全性和可行性也已得到证明。
经内窥镜的输尿管远端管理方法比输尿管远端开放手术的局部复发率更高。独立肾患者、双侧疾病患者、肾衰竭患者或无法进行大型腹部手术的并发症患者均为内窥镜切除术候选人。具有小型,低级病变的正常对侧肾患者可从内窥镜治疗中获益。远端输尿管肿瘤患者可行硬性输尿管镜治疗,上尿道肿瘤可行软性输尿管镜或经皮顺行方法治疗。
初始进行活组织检查,后通过电灼术或激光能量实现消融。以往情况病例中,上尿路上皮癌开放性肾保留手术的适用对象为大肾盂肿瘤(独立肾)患者或双侧肿瘤患者。内窥镜技术的进步,特别是经皮顺行肾脏手术,已经大大取代了这种保守的肾盂肿瘤治疗的方法。
上尿路上皮癌治疗后复发模式可分为膀胱内和膀胱外复发。上尿路上皮癌的分级和分期越高,膀胱外复发风险也就越高。上尿路上皮癌治疗患者的推荐随访方案应包括定期报告病史和体格检查、尿细胞学检查和膀胱镜检查监督(治疗后2年,3月/次,接着6月/次,若无复发,则接下来每年一次)。
在上尿路上皮癌分级较的高病例中,应进行包括胸部放射和腹部盆腔CT在内的放射学研究,遵循前2年6月/次,之后每年一次的周期。对于接受器官保留治疗的患者(已痊愈),应在前2-3年每6个月进行一次同侧内窥镜检查,之后改为每年一次。仅在患者出现骨骼疼痛或者碱性磷酸酶水平升高时才进行骨扫描。
在该病例中,经患者同意进行了膀胱镜检查,结果显示膀胱正常,未见任何外生肿瘤。CT尿路造影时发现右肾盂中的大面积充盈缺损结合尿细胞学检查阳性,将该患者确诊为上尿路上皮癌。
下列哪项说法不正确?
A、男性发生上尿路肿瘤的概率为女性的2倍
B、上尿路肿瘤鲜有发生于40岁以下人群
C、男性上尿路肿瘤的年死亡率高于女性
D、上尿路上皮癌占所有肾肿瘤的5%~7%
解析:C
上尿路肿瘤占所有肾肿瘤的5%-7%。上尿路肿瘤鲜发于40岁以下人群,该疾病患者的平均年龄为65岁。尽管男性发生上尿路肿瘤的概率是女性的2倍,但是数据显示就该疾病的年死亡率来说,女性高于男性(6.1% vs 4.4%)。女性上尿路肿瘤患者的癌症死亡率比男性高25%以上。
如今采用以下那种检查来诊断上尿路疾病?
A、静脉肾盂造影
B、CT尿路造影
C、腹部超声检查
D、腹部MRI
解析:B
传统上,使用静脉内肾盂造影术诊断上尿路肿瘤;但是CT尿路造影是现在的主要诊断方式。使用CT尿路造影检查上尿路恶性疾病的灵敏度接近100%,特异性为60%,阴性预测值为100%。